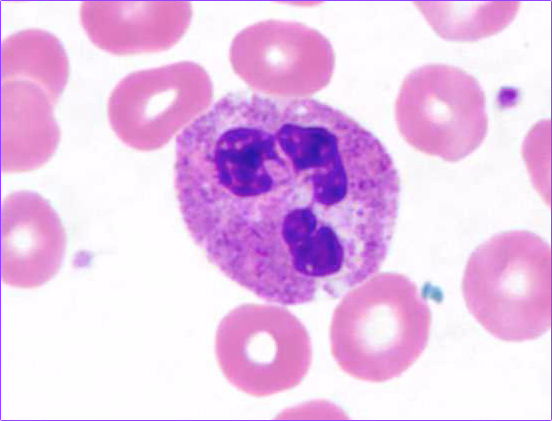

It’s been a busy time for us both and so there’s quite a lot to say – sorry!
After the chemotherapy session on Friday 1st March, Avril was due a further mammogram and an ultrasound scan the next week. On Thursday we went to Mount Alvernia Hospital at the crack of dawn (for us) for an 08:00 start.

By 08:45 we were on our way home again with the amazing news that the new scan looked exactly the same as the last routine mammogram she’d had in April 2016. Her tumour could not be seen at all and the chemo so far has worked incredibly well. Even her lymph nodes looked normal again.
Of course we’re not out of the woods just yet because that doesn’t necessarily mean there are no rogue cancer cells still lurking, just that they’re not visible; however you may recall that when the treatment started her tumour had a size of 41mm and it was clearly visible on the first scans so it’s very encouraging progress.
The chemotherapy and immunotherapy will still continue exactly as originally planned, followed by surgery. It’s fortunate that marker coils were inserted at the start of the treatment because otherwise the surgeon wouldn’t know where to start!
The day after the scans, Friday, we set our alarm again and were back at Mount Alvernia Hospital at 08:15. The second early start meant that not only did we get a parking space for the day but we also got a very nice breakfast!
It was another really long and tiring (for which read boring) day. Once again no blood samples could be extracted from the Port-a-Cath for the start-of-day tests so a cannula was used again. The blood results showed that her neutrophils level had dipped below the desirable minimum, which meant that her immune system was weaker than it should be. While the Consultant Clinical Oncologist agreed that the chemotherapy could still proceed it meant that, same as before, I had to administer a Saturday evening Lonquex injection in her lower stomach to help boost her white blood cells.
Since this was the day for another three-weekly infusion of the monoclonal antibodies (Herceptin and Perjeta), she was given additional pre-meds to avoid a repeat of the adverse reaction she had the first time – a significantly elevated body temperature.

Fortunately, the whole day went smoothly apart from just a slightly elevated temperature. The now rather dull routine was relieved by a welcome series of visitors… Alan & Sheena, Valerie and finally Amy.
We eventually got home at 19:45 for a healthy measure of gin (for me) and a not-so-healthy pizza for us both. Twelve hours in total out of the house.
Over last weekend and for the first part of this week Avril has had a few more side-effects than before. She has been noticeably more tired and has suffered for several days with aches and pains in her muscles and bones. It appears that this could be the result of the Lonquex injection I gave her on Saturday evening to boost her neutrophils as muscle pain is listed as the number one side-effect of the drug. Also, she experienced similar issues before, although to a lesser extent. So she’s been uncomfortable at times but it’s something she’s been able to cope with using mild painkillers.

Apart from the foregoing, she’s also had an itchy rash which she’s tried very hard not to scratch (mostly successfully) and has also suffered a diarrhoea/constipation “yo-yo” which has been rather challenging at times!
Today Avril saw her Consultant Surgical Oncologist to review the ultrasound scan and mammogram results from last week and he confirmed that he was very pleased with the excellent results. While cautioning that there could still be some cancerous cells present, he said that with such a dramatic reduction in the visible symptoms it was a reasonable assumption that there would be little or no active cancer remaining; and most importantly that also means the longer-term prognosis is pretty good too.
He explained a bit more about the proposed surgery which will take place about 4 weeks after the end of the chemotherapy (so probably around the middle to end of May) and which in the light of the results would be a lumpectomy. He said a marker wire would first be inserted and then about 25g of breast tissue would be removed, with a margin of healthy cells. The removed tissue is likely to be fibrous dead cancer cells and samples will be analysed within a few days to check. If there’s not enough margin, it might be necessary to have a second procedure.
During the initial breast surgery some lymph nodes will be removed at the same time. Unlike the breast tissue, the lymph nodes can be tested very quickly and the results will be available while Avril is still in the recovery area; so if necessary she will immediately be returned to the the Operating Theatre for more nodes to be removed.
The surgery should have a good cosmetic outcome and will most likely be treated as a “day case” or possibly overnight. A month afterwards she will start radiotherapy treatment lasting three to four weeks.

(photo posed by model!)
Avril’s ankle is beginning to improve with the swelling looking much less pronounced, although it’s still painful at times. She attended the Fracture Clinic at our local Royal Surrey County Hospital on Monday and they were pleased with progress. Soon she will be able to wear a lightweight “stirrup” instead of the Darth Vader boot and, having been given the doctor’s blessing, this means that she will be able to drive again, which is a great relief.
The next chemotherapy session is just two days away, so unless there’s anything significant to report there won’t be another blog post for a couple of weeks. I sense your relief!
